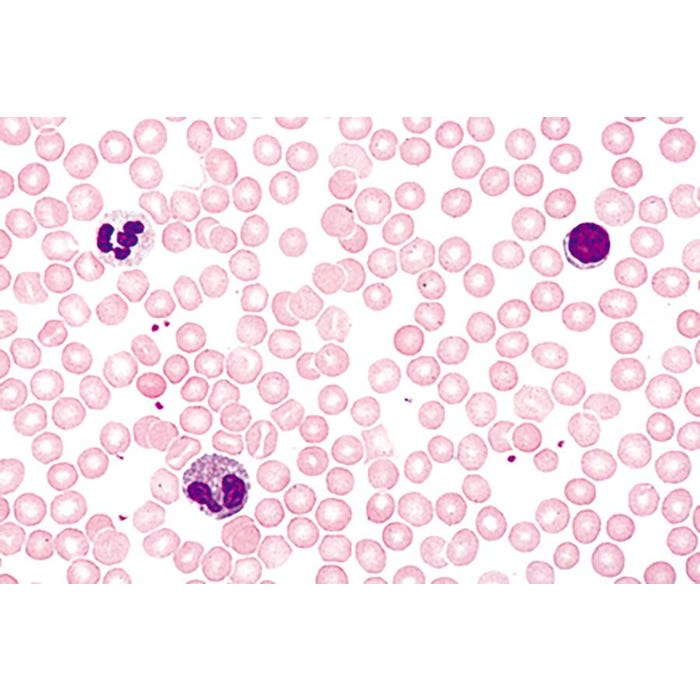
Individual Lab Slides, Item Number 1017500

Close
Shop All:Johannes Lieder
Johannes Lieder Prepared Microscope Slide, Human Blood Smear Red and White Cells
About This Item
Description
Circulatory System Human Blood Smear Red and White Cells Microscope Slide is a prepared slide with fine ground edges, measures 1 in x 3 in. These high quality microscope slides are made in Germany under rigorous scientific controls. The application of special staining techniques guarantees a clear, multicolored representation of all tissue structures.
Shipping Type:
parcel
Free Shipping:
true
Specifications
Allergens:
Contains No Allergens
Maximum Age:
12 years
UPC:
885634221393